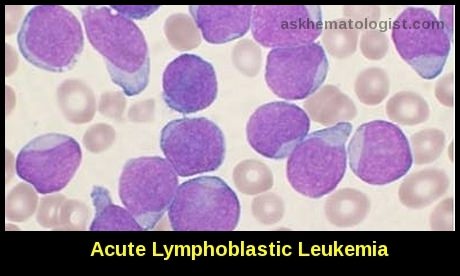
Peripheral blood smear showing numerous lymphoblasts consistent with acute lymphoblastic leukemia

Hematologic Emergencies

Rapid emergency ambulance response is critical in managing life-threatening hematologic emergencies requiring immediate medical intervention.
Hematologic emergencies represent life-threatening conditions arising from disorders of the blood, bone marrow, or lymphatic system that require immediate recognition and management to prevent serious morbidity and mortality. These emergencies may result from underlying malignancies, treatment complications, or acute derangements in hematologic function such as tumour lysis syndrome, disseminated intravascular coagulation (DIC), neutropenic sepsis, hyperleukocytosis, and severe thrombocytopenia. Early diagnosis and prompt intervention are essential to stabilise patients, prevent multiorgan failure, and improve outcomes. Understanding the clinical presentation, pathophysiology, and evidence-based management of these critical hematology conditions is vital for clinicians, particularly those caring for patients with cancer or bone marrow failure syndromes.
Patients with cancer commonly present with emergent complications of either the malignant disease itself or the therapy they are receiving. Practicing clinicians can, therefore, expect to encounter such patients in emergency departments or outpatient offices. Prompt evaluation and accurate diagnosis followed by the institution of appropriate therapy can be lifesaving and may prevent irreversible loss of organ function. A sound knowledge of oncological and hematologic emergencies is therefore very important for all healthcare professionals involved in direct patient care.
Hyperviscosity Syndrome

Fundoscopic appearance in hyperviscosity syndrome demonstrating dilated, tortuous retinal veins due to impaired microcirculatory flow.
This may be caused by several hematological conditions. Blood viscosity is a measurement of the thickness and stickiness of an individual’s blood. It is a direct measure of the ability of blood to flow through the blood vessels. Blood measurement determines how much friction the blood causes against the vessels, how hard the heart has to work to pump the blood through the body, and how much oxygen is delivered to organs and tissues. Blood viscosity is correlated with all known risk factors for cardiovascular disease. Elevated blood viscosity is a strong independent predictor of cardiovascular events.
In adults, hyperviscosity syndrome typically causes symptoms when blood viscosity is between 6 and 7, measured relative to saline, but it can be lower. Normal values are usually between 1.6 and 1.9. During treatment, the goal is to lower viscosity to the level needed to resolve an individual’s symptoms.
A marked increase in plasma proteins (for example, monoclonal immunoglobulin in myeloma) or cellular constituents (for example, white blood cells in acute leukemia) will raise the overall blood viscosity. This leads to sludging of the microcirculation and a variety of clinical manifestations. Hyperviscosity may present insidiously or acutely with neurological symptoms and signs.
Causes of hyperviscosity:
- Myeloma (especially IgA).
- Waldenström’s macroglobulinaemia (IgM paraprotein).
- Polycythaemia.
- High white cell count (hyperleucocytosis).
- Less commonly in sickle cell disease, spherocytosis, and rheumatoid disease.
Symptoms and signs of hyperviscosity:
- Mild headache.
- Neurological disturbance.
- Ataxia.
- Nystagmus.
- Vertigo.
- Confusion.
- Changes in mental state.
- Coma.
- Visual disturbance.
- Blurring of vision.
- Dilatation & segmentation of retinal veins “Sausage” appearance of retinal veins
- Risk of central retinal vein occlusion.
- Genitourinary or gastrointestinal bleeding.
Symptoms occur when the viscosity of the blood is more than four times that of water. Patients with chronic disorders such as polycythemia and myeloma are often physiologically well compensated for the degree of hyperviscosity and may complain only of mild headaches. In contrast, patients with acute leukemia and a high white cell
count may present in extremis; they become hypoxic from pulmonary involvement and are often obtunded, with a variety of neurological signs. Prompt treatment is needed to prevent permanent deficits. Elderly patients with impaired left ventricular function may experience decompensation due to their hyperviscosity, resulting in increasing congestive cardiac failure.

Leukapheresis performed to rapidly reduce elevated white blood cell counts in hyperleukocytosis associated with hematologic emergencies.
The definitive treatment of patients with hyperviscosity is dependent on the underlying pathology. For patients presenting with acute leukemia vigorous intravenous hydration and intensive chemotherapy often results in a rapid reduction in the white cell count. Leukapheresis may be used as an interim measure until chemotherapy exerts its full effect. For patients with myeloma or Waldenström’s macroglobulinemia (a low-grade lymphoma characterized by the production of monoclonal IgM, most of which is intravascular) plasmapheresis effectively reduces the paraprotein concentration.
Hypercalcemia

Relative mechanisms of hypercalcemia of malignancy, with PTHrP-mediated hypercalcemia being the most common cause.
Hypercalcemia has been reported to occur in up to 30% of patients who have a malignancy. Hypercalcemia is most common in those who have later-stage malignancies and predicts a poor prognosis for those with it. The most common causes include humoral hypercalcemia of malignancy mediated by parathyroid hormone-related peptide (PTHrP), osteolytic cytokine production, and excess 1,25-dihydroxy vitamin D production. However, the etiology is not always mediated by malignancy. Hypercalcemia can occur in those with malignancy and an additional etiology for hypercalcemia such as primary hyperparathyroidism or granulomatous diseases.
In severe cases, hypercalcemia can be associated with neurocognitive dysfunction as well as volume depletion and renal insufficiency or failure. Individual risk of hypercalcemia depends on the underlying type and stage of malignancy. The most common cancers are lung cancer, multiple myeloma, and renal cell carcinoma. These are followed by breast and colorectal cancers, and the lowest rates were reported in prostate cancer.
Hypercalcemia is categorized according to the serum total calcium level: mild hypercalcemia, 10.5 to 11.9 mg/dL; moderate hypercalcemia, 12 to 13.9 mg/dL; and severe hypercalcemia, ≥ 14 mg/dL. Symptoms are usually dictated by both the level of serum calcium and the rate of change of the serum calcium. Mild or indolent hypercalcemia can be asymptomatic, or it can be associated with mild nonspecific symptoms such as lethargy and musculoskeletal pain. In contrast, severe, rapidly progressive hypercalcemia can be associated with significant volume depletion and acute renal insufficiency, as well as dramatic neurocognitive symptoms ranging from altered mental status to coma.
Work-Up:
Obtaining a serum calcium is the first step in the workup of suspected hypercalcemia. Total serum calcium, which measures both bound and unbound calcium, is most commonly used. Forty per cent of calcium in serum is bound to albumin, and calcium homeostasis is greatly affected by albumin concentrations. Therefore, a current serum albumin level is necessary for interpretation of the serum calcium level. If the albumin is abnormal, the serum calcium should be corrected for the serum albumin. If the serum calcium is believed to be inaccurate, then ionized calcium can be used, but this also has its limitations and can be inaccurate.
The albumin–calcium system is highly sensitive to pH, and changes in pH alter the fraction of calcium ions that are bound to albumin. In respiratory alkalosis caused by hyperventilation, the ionized calcium decreases acutely, and reductions in pH can cause the ionized calcium to rise acutely, both resulting in relatively rapid shifts. Repeat measurements of calcium should be done routinely to ensure these are not spurious results.
Serum phosphorus should also be measured because hypercalcemia can be associated with both hyper- and hypophosphatemia. Once there is confirmation of hypercalcemia, then it should be determined whether it is PTH or non-PTH mediated. Because the most common cause is excess PTHrP, this should also be measured routinely. PTH and PTHrP are similar molecules; therefore, both are not concurrently elevated unless there are multiple etiologies. Additional laboratory tests include measurement of 25(OH)D and 1,25(OH)2D to evaluate for excess vitamin D production or ingestion. The pattern of PTH, PTHrP, 25(OH)D, and 1,25(OH)2D values can often be helpful when determining the cause of hypercalcemia.
Treatment:
Treatment of the underlying malignancy is always the primary goal of therapy. However, additional therapies, especially for moderate to severe hypercalcemia, are essential when simultaneously treating the underlying malignancy. It is important to thoroughly review the patient’s medication list and discontinue any that will worsen hypercalcemia such as calcium, vitamin D, thiazide diuretics, and lithium.
The severity of the hypercalcemia and associated symptoms will also dictate the timing and type of therapy. Mild asymptomatic hypercalcemia (calcium, 10.5-11.9 mg/dL) may not need to be treated until after the work-up has been completed and a diagnosis has been established. However, moderate to severe hypercalcemia (calcium > 12 mg/dL), especially when associated with severe renal or neurologic symptoms, requires prompt, often inpatient management.

Mechanism-based management of hypercalcemia targeting renal excretion, bone resorption, intestinal absorption, and PTH-related pathways.
Essentially all patients with malignancy-associated hypercalcemia have increased osteoclastic bone resorption and increased renal tubular calcium reabsorption. Hence, medical therapy is aimed at inhibiting bone resorption and promoting renal calcium excretion. Reducing intestinal calcium reabsorption is also important in those with increased extrarenal 1,25(OH)2D production.
The initial step in the care of severely hypercalcemic patients is hydration and forced calciuresis. Because most of these patients are profoundly dehydrated, 0.9 normal saline is the crystalloid of choice for rehydration. Hydration helps decrease the calcium level through dilution. The expansion of extracellular volume also increases the renal calcium clearance. The rate of fluid therapy is based upon the following:
- Degree of hypercalcemia.
- Severity of dehydration.
- The ability of the patient to tolerate rehydration – Vigilance to prevent volume overload is critical.
Hydration is ineffective in patients with kidney failure because diuresis is impossible. Dialysis is necessary to correct hypercalcemia in patients with renal failure.
Loop diuretics
A loop diuretic (eg, furosemide) may be used with hydration to increase calcium excretion. This may also prevent volume overload during therapy.
In contrast to loop diuretics, avoid thiazide diuretics because they increase the reabsorption of calcium.
Bisphosphates – These agents will inhibit osteoclast activity for up to a month. However, these agents may take 48-72 hours before reaching full therapeutic effect.
Corticosteroids are generally ineffective except in certain specific instances e.g. myeloma and are best avoided in the routine treatment of undiagnosed hypercalcemia.
Sickle Cell Crisis
The sickling disorders (Hb SS, Hb SC, Hb S/â thalassemia, and Hb SD) are inherited structural hemoglobin variants. Homozygous Hb SS, in particular, is associated with several complications, including recurrent vaso-occlusive crises, leg ulcers, renal impairment, hyposplenism, and retinopathy.

Sickled erythrocytes causing microvascular obstruction and impaired blood flow during a vaso-occlusive sickle crisis.
Sickle cell disease (HbS) is a severe hereditary form of anemia in which a mutated form of hemoglobin distorts the red blood cells (RBC’s) into a crescent shape at low oxygen levels. The disease is commonest among those of African descent.
Sickle cell crises include vaso-occlusive, aplastic, sequestration, and hemolytic episodes. The chest syndrome and the girdle syndrome are more severe forms of crisis associated with higher morbidity and mortality. Crises may be precipitated by dehydration or infection; in many cases no obvious precipitant is found.
Vaso-occlusive episodes: in any tissue but especially bones, chest, and abdomen (e.g. splenic infarcts); in cerebral vessels, leading to stroke.
Aplastic episodes: in parvovirus B19 infection.
Sequestration episodes: particularly in infants and young children; massive pooling of red cells in spleen and other organs, leading to a precipitous drop in hemoglobin.
Hemolytic episodes: further reduction in the lifespan of red cells, leading to worsening anemia and features of hemolysis.
Chest syndrome: pleuritic pain and fever may mimic pneumonia or pulmonary embolism; progressive respiratory failure.
The aim of treatment is to break the vicious cycle of sickling: sickling results in hypoxia and acidosis, which in turn precipitate further sickling. This is exacerbated by dehydration,
and a high fluid intake (70 ml/kg/24 h) is the cornerstone of management.

The self-perpetuating cycle of hypoxia and acidosis promoting red blood cell sickling in sickle cell disease.
Also imperative in managing sickle cell crises is adequate pain relief—opiates, by continuous subcutaneous or intravenous infusions, may be needed. Arterial blood gas pressures should be performed and oxygen therapy prescribed if hypoxia is confirmed.
It should be remembered that sickle cell patients are functionally asplenic and that infection is a common precipitant of crises. Broad-spectrum antibiotics should be started while waiting for the results of blood and urine cultures.
It is important to recognize the patients who need urgent exchange transfusion to reduce the level of Hb S to below 30%. Transfusion should be started promptly if the patient has a
severe chest syndrome (with pronounced hypoxia), has had a cardiovascular accident, or has priapism.
Spinal Cord Compression
Some patients may present at the hematology clinic with metastatic tumor deposits—for example, lymphoma or plasmacytoma—resulting in cord compression.

MRI demonstrating spinal cord compression caused by an epidural mass, a neurologic emergency in oncology and hematology.
If cord compression is suspected the patient should be investigated with plain spinal radiography, which may show evidence of lytic lesions (as, for example, in myeloma). The definitive investigation is magnetic resonance imaging to delineate the level of the lesion and to help plan further treatment.
In a patient presenting de novo with cord compression further investigations (protein electrophoresis, measurement of prostatic specific antigen and other tumor markers, and chest radiography) are needed to elucidate the underlying cause.
A formal biopsy of the lesion may be needed to determine the underlying pathology.
In an acute presentation, high dose dexamethasone (for example, 4 mg four times daily) is given. Further management depends on the underlying cause, but often a combination of chemotherapy and radiotherapy is given.
Neutropenic Sepsis & Immune Suppression
Patients with a variety of hematological diseases are immunocompromised due to either their underlying disease or the treatment required for the condition. For example, patients
with myeloma often present with recurrent infection as a result of the reduction in normal immunoglobulin concentrations associated with the paraproteinaemia. This susceptibility is
compounded by the use of combination chemotherapy, which may render them neutropenic.
Several hematological disorders are now routinely treated in outpatient clinics with aggressive chemotherapy, so some patients in the community may be neutropenic as a result of this. Patients are educated to seek medical advice immediately if they develop any infection since Gram-negative septicemia may lead rapidly to death. For patients receiving intensive chemotherapy presenting with fever while neutropenic, broad-spectrum antibiotics should be started immediately. The choice of antibiotics depends on local microbiological advice in the light of the sensitivities of the micro-organisms in the region.
Pseudomonas aeruginosa was the most common infectious pathogen in patients with hematologic/oncologic disorders during the 1960s and 1970s; P. aeruginosa infections also showed higher mortality rates compared with other bacterial infections. After the introduction of antibiotics with anti-pseudomonal effects e.g. Tazocin (piperacillin and tazobactam) and the increased frequency of Gram-positive bacterial infections in the 1980s, the proportion of P. aeruginosa infections in immunocompromised patients was reduced. However, P. aeruginosa is still the third most common Gram-negative cause of bacteremia in febrile neutropenic patients, after Klebsiella pneumoniae and Escherichia coli. In addition, P. aeruginosa bacteremia resulted in approximately 30% mortality in patients with underlying hematologic/oncologic disorders in the 2000s.
Patients with chronic lymphocytic leukemia often have recurrent infection in the absence of neutropenia, because of the accompanying hypogammaglobulinemia seen in this disorder. Frequent courses of antibiotics are often required. The role of regular intravenous immunoglobulin infusions to “boost” their immunity is debatable. Patients with chronic
lymphocytic leukemia may develop severe recurrent herpes zoster infections. Prompt treatment with aciclovir should always be given at the first suspicion of any herpetic lesions developing, and hospital referral for intravenous antibiotics and aciclovir should be considered if the lesions are not confined to a single dermatome or are in a delicate area—for example, ophthalmic division of trigeminal nerve.

Herpes zoster ophthalmicus affecting the ophthalmic division of the trigeminal nerve with ocular involvement.
Patients who are functionally or anatomically asplenic are at high risk of infection with encapsulated organisms, especially Streptococcus pneumoniae. Penicillin prophylaxis and immunization reduces the incidence of these infections but does not abolish the risk
completely. If any of these patients becomes acutely unwell the prompt administration of 1200 mg benzylpenicillin (if no history of allergy to penicillin) and prompt referral for further treatment may be life-saving.
Risks of infection in patients with no spleen or hypofunctioning spleen:
- Encapsulated organisms—for example, Streptococcus pneumoniae
(60%), Haemophilus influenzae type b, Neisseria meningitidis. - Less commonly—Escherichia coli, malaria, babesiosis, Capnocytophaga
canimorsus.
Recommendations for patients with no spleen or hypofunctioning spleen:
- Pneumococcal vaccine (Pneumovax II) 0.5 ml—two weeks before splenectomy or as soon as possible after splenectomy (for example, if emergency splenectomy is performed); reimmunize every 5-10 years.
- H influenzae type b (Hib) vaccine 0.5 ml.
- Meningococcal polysaccharide vaccine for N meningitidis type A and C 0.5 ml.
- Penicillin as prophylaxis (250 mg twice daily—for life).
The three vaccines (subcutaneous or intramuscular) may be given at the same time,
but different sites should be used.
Tumor Lysis Syndrome
Tumor lysis syndrome (TLS) refers to the metabolic disturbances that occur when large numbers of neoplastic cells are killed rapidly, leading to the release of intracellular ions and metabolic byproducts into the systemic circulation. These electrolyte and metabolic disturbances can progress to clinical toxic effects, including renal insufficiency, cardiac arrhythmias, seizures, and death due to multiorgan failure.

Characteristic ECG findings in hyperkalemia including tall peaked T waves and progressive QRS widening.
The tumor lysis syndrome is the most common disease-related emergency encountered by physicians caring for children or adults with hematologic cancers.
Although it develops most often in patients with non-Hodgkin’s lymphoma or acute leukemia, its frequency is increasing among patients who have tumors that used to be only rarely associated with this complication.
When cancer cells break down and die, they release substances into the blood. If cancer cells break down so quickly that the kidneys can’t remove these substances from the blood, it can lead to tumor lysis syndrome (TLS).
Clinically, the syndrome is characterized by rapid development of hyperuricemia, hyperkalemia, hyperphosphatemia, hypocalcemia, and acute kidney injury.
Tumor lysis syndrome arises most commonly after the start of initial chemotherapeutic treatment, but spontaneous cases have increasingly been documented in patients with high-grade hematologic malignancies. It can occur within a few hours of treatment, but it is most often seen 48–72 hours (2–3 days) after treatment starts.
TLS has been linked with other treatments, including radiation therapy, corticosteroids, hormonal therapy, and biological therapy.
Although tumor lysis syndrome has been reported with virtually every type of tumor, it is typically associated with bulky, rapidly proliferating, treatment-responsive tumors —typically, acute leukemias and high-grade non-Hodgkin lymphomas such as Burkitt lymphoma.
Because tumor lysis syndrome is potentially lethal, the main principles of management are by identification of high-risk patients with initiation of preventive therapy and early recognition of metabolic and renal complications and the prompt administration of supportive care, including hemodialysis.
Patients due to receive chemotherapy for any hematological malignancy should have a risk assessment for TLS:
Low-risk patients can be managed with careful attention to the monitoring and measurement of fluid status and laboratory results with a low threshold for recourse to intravenous fluids and consideration of allopurinol if needed.
Intermediate risk patients should be offered up to 7 days of allopurinol prophylaxis along with increased hydration post-initiation of treatment or until the risk of TLS has resolved.
High-risk patients should be offered prophylaxis with rasburicase along with increased hydration.
In high-risk adults, in the absence of established clinical or laboratory TLS, TLS can be prevented in the majority of patients using a single fixed dose of 3 mg rasburicase, but this must be followed by careful monitoring of clinical and biochemical parameters with repeat dosing if required.
In high-risk children, in the absence of established clinical or laboratory TLS, prophylaxis can be achieved in the majority of patients using a single dose of 0·2 mg/kg rasburicase.
The management of established TLS requires a multidisciplinary approach with involvement of hematologists, nephrologists and intensive care physicians.
Potassium must not be added to the hydration fluid.
Alkalinization of the urine is not recommended in the treatment of TLS.
Allopurinol, whilst useful in the prophylactic setting, is not the drug of choice in established TLS except in the presence of G6PD deficiency or allergy to rasburicase.
In the absence of contraindications, patients with established TLS should be given rasburicase at a dose of 0·2 mg/kg/day. The duration of treatment should be determined by the clinical response.
Asymptomatic hypocalcemia should not be treated. Symptomatic hypocalcemia should be treated with a short infusion of calcium gluconate at a dose applicable to the age/weight of the patient and close monitoring of calcium levels, phosphate levels and renal function.
Patients with potassium levels ≥6 mmol/l or having experienced a 25% increase in potassium level from baseline should have cardiac monitoring.
Intractable fluid overload, hyperkalemia, hyperuricemia, hyperphosphatemia or hypocalcemia are indications for renal dialysis.
Dialysis should continue until there is adequate recovery of renal function, resolution of severe electrolyte imbalance and recovery of urine output.
Balanced or isotonic solutions should be administered to maintain urine output >4 ml/kg/h for infants and 100 ml/m2/h for older patients.
Disseminated intravascular coagulation
Disseminated intravascular coagulation (DIC) describes the syndrome of widespread intravascular coagulation induced by blood procoagulants either introduced into or produced in the bloodstream. These coagulant proteins overcome the normal physiological anticoagulant mechanisms. The overall result, irrespective of cause, is widespread tissue ischemia (due to clot formation, thrombi) and bleeding (due to consumption of clotting factors, platelets, and the production of breakdown products that further inhibit the coagulation pathway). DIC is estimated to occur in 1% of hospitalized patients.

Microvascular clot formation in disseminated intravascular coagulation leading to simultaneous thrombosis and bleeding.
Causes of acute disseminated intravascular coagulation:
Infection—Especially Gram-negative infections, endotoxic shock.
Obstetric—Placental abruption, intrauterine fetal death, severe pre-eclampsia or eclampsia, amniotic fluid embolism.
Trauma—Especially head injury, burns.
Malignancy—Carcinoma of prostate, lung, pancreas, ovary, and gastrointestinal tract.
Miscellaneous—Transfusion with incompatible blood group, drug reactions, hypothermia, venomous snake bite, transplant rejection.
Vascular—Aortic aneurysm, giant haemangioma.
Clinical features of disseminated intravascular coagulation:
The diagnosis of disseminated intravascular coagulation is initially clinical and is confirmed by various blood tests.
Bleeding
- Spontaneous bruising.
- Petechiae.
- Prolonged bleeding from venepuncture sites, arterial lines, etc.
- Bleeding into gastrointestinal tract or lungs.
- Secondary bleeding after surgery.
- Coma (intracerebral bleeding).
Clotting
- Acute renal failure (ischemia of renal cortex).
- Venous thromboembolism.
- Skin necrosis or gangrene.
- Liver failure (due to infection and hypotension).
- Coma (cerebral infarction).
Shock
Due to underlying disease together with disseminated intravascular coagulation.
Central nervous system
- Transient neurological symptoms and signs.
- Coma.
- Delirium.
Lungs
- Transient hypoxemia.
- Pulmonary hemorrhage.
- Adult respiratory distress syndrome.
Investigations:
- Full blood count: decreased platelet count.
- Blood Smear: Fragmented RBCs (schistocytes & irregularly contracted cells).
- Prothrombin time (PT): increased.
- Activated partial thromboplastin time (APTT): increased.
- Fibrinogen: decreased.
- Fibrin degradation products/D dimers: increased.
Urea and electrolytes, liver function tests, blood cultures, pulse oximetry (oxygen saturation).

Schistocytes on peripheral smear indicating microangiopathic hemolysis in disseminated intravascular coagulation.
Treatment is primarily directed at the underlying cause—for example, the use of antibiotics when infection is suspected, or removal of fetus and placenta with placental abruption or
retained dead fetus syndrome. Disseminated intravascular coagulation generally resolves fairly quickly after removal of the underlying cause.
Interim supportive measures, such as intravenous hydration and oxygen therapy, are important. Correction of the coagulopathy entails the use of fresh frozen plasma (FFP), cryoprecipitate, and platelet transfusion. No uniform protocol exists for transfusing blood and blood products. Instead, for each patient, the quantity of blood product used is decided after clinical evaluation and serial coagulation assays. The use of intravenous heparin to treat DIC remains controversial. Some evidence supports the value of heparin in the management of acute promyelocytic leukemia, the dead fetus syndrome, and aortic
aneurysm before resection. For other causes of disseminated intravascular coagulation, the use of heparin is more uncertain and may actually worsen the bleeding.
Summary:
Hematologic emergencies are acute, life-threatening complications arising from blood disorders, hematologic malignancies, or treatment-related toxicities that require urgent recognition and immediate medical intervention. These conditions may present with organ dysfunction, severe metabolic derangements, microvascular obstruction, or catastrophic bleeding.
Common hematologic emergencies include hyperviscosity syndrome, hypercalcemia of malignancy, tumor lysis syndrome, hyperkalemia, neutropenic sepsis, vaso-occlusive sickle cell crisis, spinal cord compression, disseminated intravascular coagulation (DIC), hyperleukocytosis requiring leukapheresis, and aggressive leukemias such as acute lymphoblastic leukemia (ALL) and Burkitt lymphoma.
Key pathophysiologic mechanisms include:
- Microvascular obstruction (hyperviscosity, sickling, leukostasis)
- Excessive coagulation activation (DIC)
- Rapid tumor cell breakdown (tumor lysis syndrome)
- Severe electrolyte imbalance (hyperkalemia, hypercalcemia)
- Profound immunosuppression (neutropenia with mucosal ulcers and viral reactivation)
- Rapid tumor expansion causing neurologic compromise (spinal cord compression)
Prompt diagnosis through clinical assessment, laboratory testing, peripheral smear examination, ECG monitoring, and urgent imaging (e.g., MRI in spinal cord compression) is critical. Early intervention — including IV fluids, corticosteroids, cytoreductive therapy, leukapheresis, plasmapheresis, dialysis, antimicrobial therapy, blood product support, and definitive chemotherapy — significantly reduces morbidity and mortality.
Hematologic emergencies represent a cornerstone of acute hematology and require coordinated multidisciplinary management.
Questions and Answers:
What are hematologic emergencies?
Hematologic emergencies are life-threatening complications related to blood disorders or hematologic cancers that require immediate medical intervention to prevent organ failure, severe bleeding, or death.
What is hyperviscosity syndrome and why is it dangerous?
Hyperviscosity syndrome occurs when blood becomes excessively thick due to high levels of immunoglobulins or blood cells, impairing microcirculation. It can cause visual disturbances, neurologic deficits, bleeding, and requires urgent plasmapheresis.
When is leukapheresis indicated?
Leukapheresis is indicated in severe hyperleukocytosis with leukostasis, particularly in acute leukemia. It is also used for peripheral blood stem cell collection and CAR-T cell therapy harvesting.
How does hypercalcemia of malignancy present?
Hypercalcemia may present with confusion, dehydration, arrhythmias, and renal failure. It is commonly caused by PTHrP secretion, osteolytic metastases, or excess vitamin D production. Treatment includes IV fluids, bisphosphonates, calcitonin, and denosumab.
Why is hyperkalemia a hematologic emergency?
Hyperkalemia can cause fatal cardiac arrhythmias. It commonly occurs in tumor lysis syndrome, hemolysis, or renal failure. ECG changes include peaked T waves and QRS widening. Immediate treatment includes IV calcium, insulin with glucose, and potassium removal.
What causes vaso-occlusive sickle cell crisis?
Vaso-occlusive crisis results from sickled red blood cells obstructing microvasculature, leading to ischemia and severe pain. Hypoxia and acidosis worsen sickling in a vicious cycle.
What are signs of spinal cord compression in hematologic malignancies?
Back pain, limb weakness, sensory deficits, and bladder dysfunction may indicate spinal cord compression. Urgent MRI and immediate corticosteroid therapy are essential.
What is disseminated intravascular coagulation (DIC)?
DIC is a consumptive coagulopathy characterized by widespread clot formation and simultaneous bleeding. Peripheral smear may show schistocytes. It requires urgent treatment of the underlying cause.
Why are mouth ulcers important in neutropenic patients?
Oral ulcers in neutropenic patients may signal mucosal barrier injury and risk of neutropenic sepsis, which requires immediate broad-spectrum antibiotics.
Why is Burkitt lymphoma considered an emergency?
Burkitt lymphoma grows extremely rapidly and carries a high risk of tumor lysis syndrome. Immediate chemotherapy initiation and metabolic monitoring are critical.
What laboratory tests are essential in suspected hematologic emergencies?
Complete blood count, peripheral smear, coagulation profile, electrolytes, renal function, LDH, uric acid, fibrinogen, D-dimer, and ECG monitoring are fundamental investigations.
References:
Halfdanarson TR, Hogan WJ, Madsen BE. Emergencies in hematology and oncology. Mayo Clin Proc. 2017. Available from: https://www.mayoclinicproceedings.org/article/S0025-6196(17)30139-8/pdf
Frewin R, Henson A, Provan D, Tung K. Haematological emergencies. ABC of Clinical Haematology. BMJ. Available from: https://www.ncbi.nlm.nih.gov/pmc/articles/PMC2126550/pdf/9158472.pdf
Goldner W. Cancer-related hypercalcemia. J Oncol Pract. 2016;12(5):426–432. Available from: http://ascopubs.org/doi/full/10.1200/jop.2016.011155
Pi J, Kang Y, Smith M, et al. A review of the treatment of oncologic emergencies. J Oncol Pharm Pract. 2015;1078155215605661.
Cho KC. Electrolyte & acid-base disorders. In: Papadakis MA, McPhee SJ, Rabow MW, editors. CURRENT Medical Diagnosis & Treatment. New York: McGraw-Hill; 2013. Chapter 21.
Thalassinos NC, Joplin GF. Failure of corticosteroid therapy to correct the hypercalcaemia of malignant disease. Lancet. 1970;2(7672):537–538.
Kim HS, Park BK, Kim SK, et al. Clinical characteristics and outcomes of Pseudomonas aeruginosa bacteremia in febrile neutropenic children and adolescents. BMC Infect Dis. 2017;17:500. doi:10.1186/s12879-017-2597-0
Todeschini G, Vinante F, Benini F, et al. Gram-negative septicemia in patients with hematologic malignancies. Eur J Cancer Clin Oncol. 1984;20:327–331. doi:10.1016/0277-5379(84)90077-4
Cattaneo C, Antoniazzi F, Casari S, et al. Pseudomonas aeruginosa bloodstream infections among hematological patients. Ann Hematol. 2012;91:1299–1304. doi:10.1007/s00277-012-1424-3
Guidelines for the prevention and treatment of infection in patients with an absent or dysfunctional spleen. BMJ. 1996;312:430–434.


Request Online Consultation With Dr M Abdou
Fee: US$100
Secure payment via PayPal (credit and debit cards accepted)
Pay Now